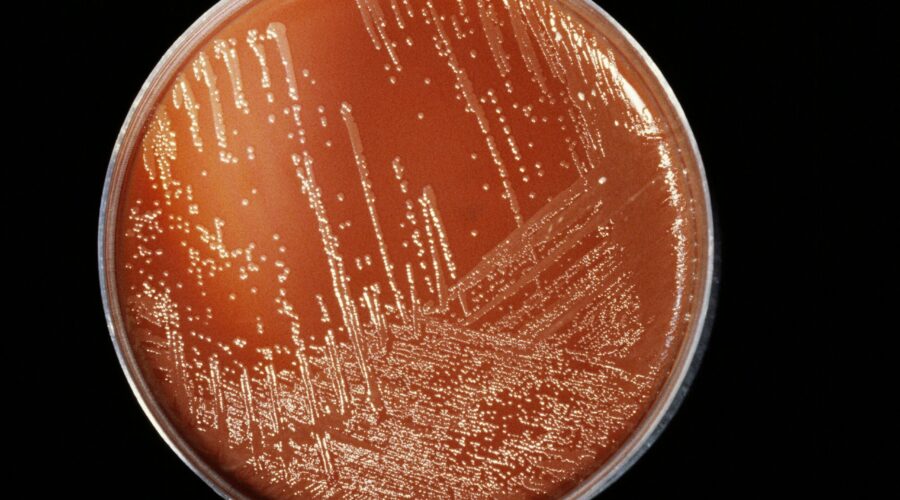
Bebê de 1 ano morre com suspeita de meningite em Guarujá e outro caso é confirmado no litoral de SP

Bebê de 1 ano morre com suspeita de meningite em Guarujá e outro caso é confirmado no litoral de SP
Bebê de um ano morre e duas crianças estão internadas com suspeita de meningite em Guarujá
Um menino de 1 ano morreu com suspeita de meningite em Guarujá, no litoral de São Paulo. A informação foi confirmada à TV Tribuna, afiliada da Globo, pelo secretário municipal de Saúde, Fábio Mesquita, que disse que a administração investiga o caso.
A morte ocorreu na manhã da última quarta-feira (12). A criança estava internada no Hospital Santo Amaro (HSA) após ser transferida da UPA Rodoviária com suspeita da doença.
De acordo com Mesquita, a morte ocorreu cerca de 48 horas após a transferência. Ainda conforme o secretário, foram solicitados exames junto ao Instituto Adolfo Lutz para identificar a causa da morte.
Clique aqui para seguir o canal do g1 Santos no WhatsApp.
A suspeita de meningite se baseia no quadro clínico, segundo Mesquita. A criança havia perdido a consciência, estava desnutrida e vomitando.
Bactéria da meningite
CNRI/CNX/Science Photo Library/Arquivo AFP
Caso suspeito
Outro menino, de 1 ano e 1 mês, está internado no HSA com diagnóstico positivo para meningite bacteriana. Ele deu entrada na unidade na segunda-feira (10) e é acompanhado pela pediatria.
Por esse motivo, medidas preventivas foram adotadas nas creches frequentadas pelas crianças. Segundo o secretário, estão sendo oferecidos medicamentos àqueles que tiveram contato com os infectados.
“Nós estamos pedindo para as crianças trazerem as carteiras de vacinação nas escolas e todas aquelas que os pais autorizarem, por escrito ou pessoalmente, a gente vai vacinar, vai deixar com a carteira em dia, para que as crianças estejam atualizadas”, disse.
Vítima está internada no Hospital Santo Amaro, em Guarujá (SP)
Matheus Tagé/Arquivo/ A Tribuna Jornal
Mortes na região
Uma menina de 11 anos, estudante da rede pública de Praia Grande, morreu no dia 26 de outubro, diagnosticada com meningite tipo C. Milena do Nascimento Alvarenga estava hospitalizada no Hospital Irmã Dulce.
Milena do Nascimento morreu no domingo de meningite tipo C. À direita, uma ilustração baseada em observações com microscópio eletrônico mostra a bactéria Neisseria meningitidis, que causa a meningite meningocócica
Reprodução e CDC
A Prefeitura de Santos também informou que, em julho deste ano, um homem de 57 anos morreu por conta da doença. Segundo o município, outros seis casos foram registrados em 2025.
VÍDEOS: g1 em 1 minuto Santos
Fonte Oficial